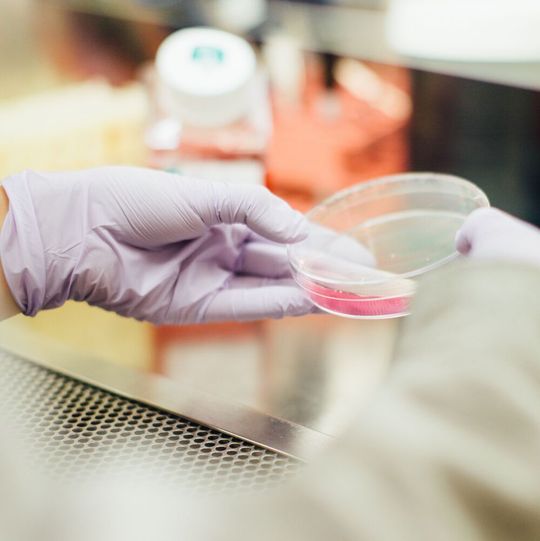

Biotechnologie Sartorius übernimmt Zellkulturspezialisten Xell
Durch die Übernahme von Xell, baut Sartorius sein Zellkulturmediengeschäfts mit Fokus auf Medien für Gentherapien und Impfstoffe weiter aus. Der Konzern erweitert damit vor allem seine Kapazitäten für die Fertigung von Pulver- und Flüssigmedien.
Anbieter zum Thema
Göttingen – Das Life-Science-Unternehmen Sartorius hat über seinen Teilkonzern Sartorius Stedim Biotech den Zellkulturspezialisten Xell mit Sitz in Bielefeld, Deutschland, übernommen. Xell entwickelt, produziert und vermarktet Nährmedien für Zellkulturen, insbesondere zur Herstellung von viralen Vektoren, die bei Gentherapien und Impfstoffen zum Einsatz kommen. Überdies bietet das Unternehmen verschiedene Analytik-Services an, um Medienkomponenten zu charakterisieren und zu quantifizieren sowie die Medienrezepturen zu optimieren.
Xell war bisher in Privatbesitz, beschäftigt rund 35 Mitarbeiterinnen und Mitarbeiter und wird im Jahr 2021 voraussichtlich einen Umsatz von ca. fünf Millionen Euro bei starken Wachstumsraten und einer deutlich zweistelligen Ebitda-Marge erwirtschaften. Am Firmensitz wurde kürzlich eine sehr umfangreiche und hochmoderne Kapazitätserweiterung abgeschlossen. Die Vertragspartner einigten sich auf einen Kaufpreis von rund 50 Millionen Euro zuzüglich zweier Earn-Out-Komponenten, die von der Erreichung definierter Umsatzziele in den Jahren 2022 bis 2025 abhängig sind.
(ID:47549461)